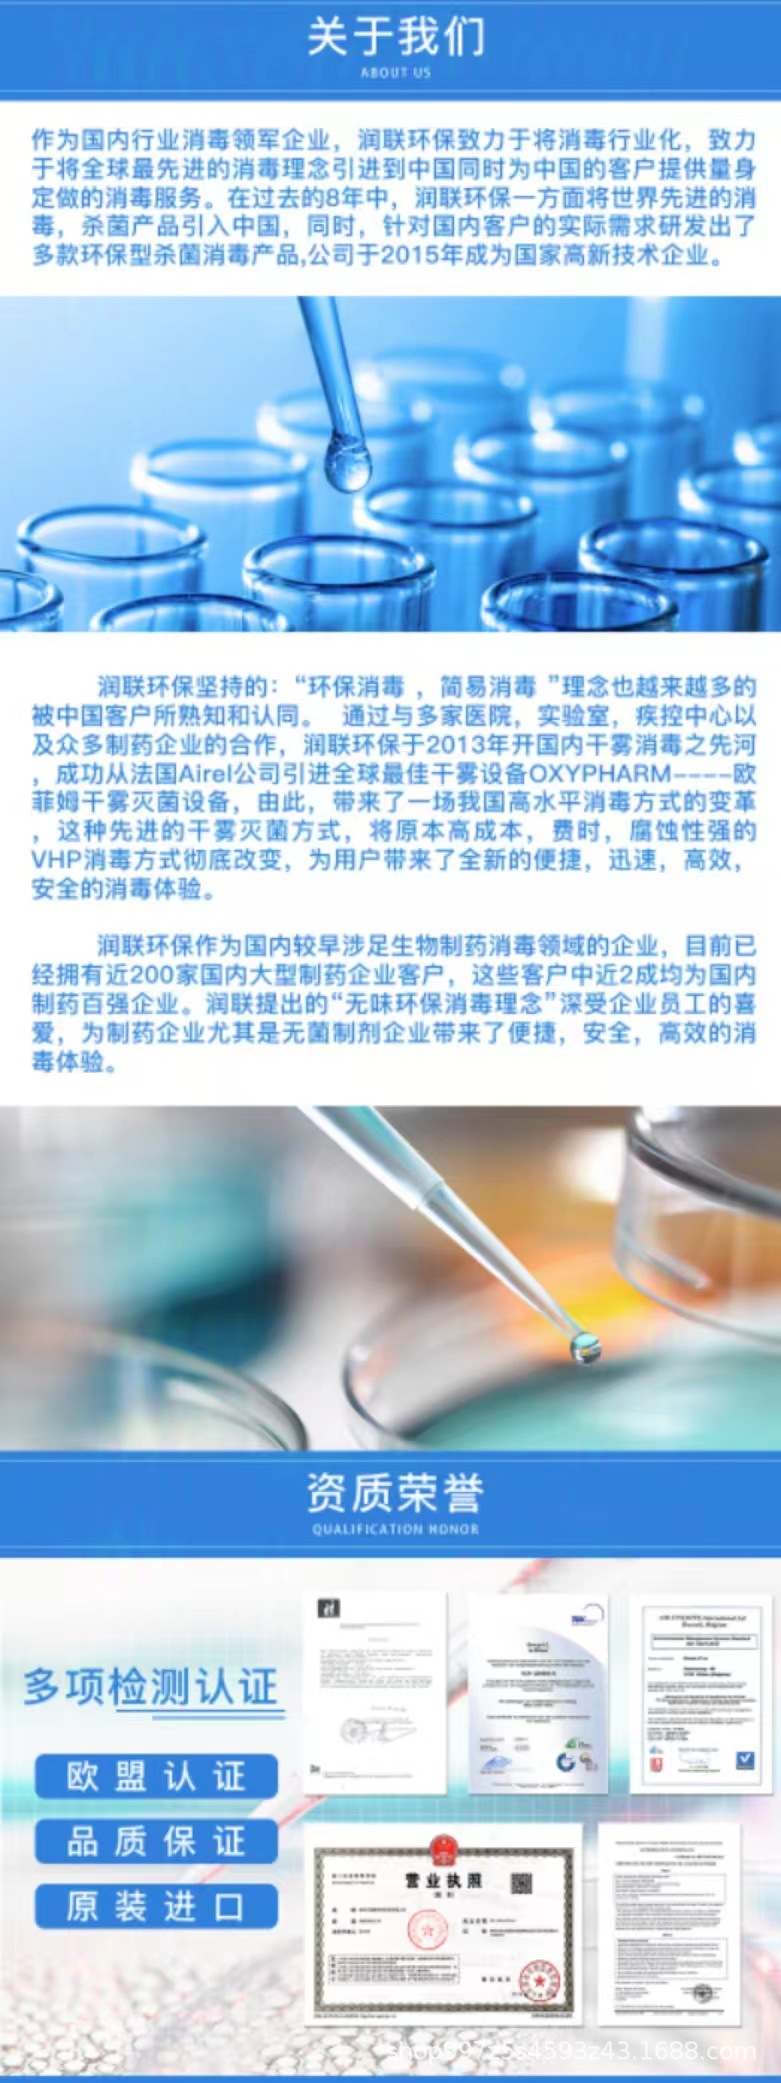
undefined

Хлеб запрещен с натриевым дегидроацетатом, новый пищевой бактерицид, дезинфицирующее средство, продлевает срок хранения и безопасность хлеба
Цена
¥380.00 / ≈ 4 622 ₽
MOQ: 1 pcs
1шт - ¥380.00
Продавец
润联生命科学(郑州)有限公司
Рейтинг
0
Продано
0
Всего
В наличии
199998
SKU суммарно
Offer ID: 895609484395
Оформить заказ
Спецификация:
| Изображение | Спецификация | Цена (CNY / RUB) | В наличии | SKU ID | Кол-во / Корзина |
|---|---|---|---|---|---|
📦 | 1kg/bottle | ¥380.0 / ≈ 4 622 ₽ | 99999 | 5746616693272 | |
📦 | 12kg/carton | ¥4080.0 / ≈ 49 627 ₽ | 99999 | 5746616693273 |
Статистика продавца
3.5
Сервис
Источник: API 1688
3.0
Логистика
Источник: API 1688
5.0
Споры
Источник: API 1688
3.0
Оформление
Источник: API 1688
3.0
Консультация
Источник: API 1688
0%
Повторные покупки
Источник: API 1688
3.6
Постпродажное
Источник: API 1688
Свойства товара
Название продукта Bread food grade sterilization preservative
Код CAS 1
Класс продукта Premium product
Содержание ≥ 50
Внедрение стандартов качества 1
Спецификации упаковки 1KG
Производитель/страна происхождения Belgium
Бренд Novo
Код продукта NW100
Является ли это опасным химическим веществом? No
Импортный: Да/Нет No
Модель NW100
Описание товара